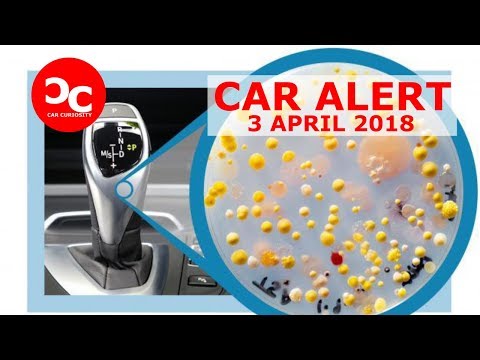

I'm Jessica and I'm getting a BBL today.
I got my first breast augmentation when I was 18.
And then when the bandages came off and I got to see them I was just kind of obsessed
with getting work done I guess to accentuate parts of my body that I felt were lacking.
I grew up here in Florida a little bit north of Miami in Clearwater.
I was very boob envy when I was younger and
I got my first breast augmentation when I was 18
and they were small implants and they fit my frame and they looked very cute.
When I was 21 I got a second breast augmentation because I had put on some weight and my body
just changed so I felt it was a better fit at that point.
And that is what kind of lead me now here to get a Brazilian Butt Lift
to make my midsection a little bit smaller and my hips a little bit wider to be more
congruent with the rest of my body.
Even out my figure and get a more hourglass shape.
I chose to have my surgery done with Dr. Mendieta because I am so impressed with the natural
look that he achieves in all of his patients.
I'm Dr. Constantino Mendieta a board certified plastic surgeon in Miami, Florida,
the land of the bikinis.
My specialty really has focused around the buttock area.
It's become a sub-specialty within plastic surgery.
So today's case with Jessica was amazing because she had incredible anatomy to her.
The problem was, is that her fat wasn't distributed right.
So it's like having a gorgeous house
but you got all these trees in the front and you can't see it.
Well I removed the trees so you could appreciate the house.
It's not just about the butt, it's about the entire body.
It's about looking good when you're walking into a room but looking even better
when you're walking out of that room.
So it's a front and back procedure.
My mother is Caucasian and my father is Puerto Rican and on the Puerto Rican side all of the
women have round beautiful booties and thick legs and tiny waists.
So I'm hoping that today I'll be more like the family.
In the old days it was just about removing fat, there was no artistry to it.
And now we've found different anatomical styles that people may like.
So here's what we did with Jessica today in terms of her case here.
We gave her general anesthesia and then we infiltrated this special fluid
called tumescent fluid, which has epinephrine and lidocaine.
Lidocaine's for the pain, epinephrine so that it constricts the blood vessels and you don't
bleed as much.
Then once I extracted and contoured the entire abdomen I proceeded to reshape the buttock.
I used that same vibrating cannula to re-inject the fat.
Once I reshape the butt, now I make the butt bigger.
And that's when I added fat to the central part of the muscle to expand it.
So look at all the volume that she has here, very little volume there so it's totally different.
Look at her waistline.
I've been able to work that waist, so I've really been able to contour look how flat
that is there and look how flat it is right there.
So it's very very different.
I then went ahead and started re-contouring and re-suctioning to accentuate the areas
that I wanted to accentuate and then we put sutures to close the incisions.
We put the body garment on her.
And away she goes to being first in line at every discotheque.
So I am day 2 after my BBL.
I'm feeling pretty good, a little more rough than yesterday.
Yesterday I was just really tired and I didn't really wanna do much I didn't move around
too much but I wasn't in any pain like at all.
I did notice I am so tired I cannot stand for more than like 5 minutes
without getting fatigued.
So that's probably the biggest adjustment.
And I got to get my garment off and take pictures and look at myself and the results are amazing
I can't wait for the swelling to go down but I can definitely see the shape changing.
And that is so exciting and it makes it all worth it.
Doing well how are you?
Good sweetheart how are you doing?
I'm doing good.
It has been 2 months since my Brazilian Butt Lift
and I have been loving every second of it.
I'm not shy about my plastic surgery but I don't really like to show it off
until I'm recovered.
Since surgery my whole silhouette has changed really.
My waist has shrunk.
None of my clothes fit right anymore because my waist is so small.
so it's kind of difficult to actually find clothes right now but I feel like it's a good
problem to have.
The whole liposuction just really shaped me really pretty I think.
And it's very feminine and kind of sexy.
I feel ecstatic, I feel happy I feel anxious to show off my results.
I feel like this is the body I was supposed to have.
It fits with the rest of me.
It fits with my family and it just fits with everything I want to do in my life.

For more infomation >> Checking in a Moscow hotel (the second part is SLOW, turn on subtitles). - Duration: 1:46. 
Không có nhận xét nào:
Đăng nhận xét